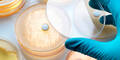
Antibiotika

Klimawandel fördert Ausbreitung - Problem Erkennung: Ärzte denken nicht immer an Tropenkrankheiten, wenn sie einen infizierten Patienten vor sich haben.
Malaria, Chikungunya, Zika: Es gibt Urlaubsmitbringsel, auf die man gut verzichten kann. Doch immer mehr Touristen reisen in Regionen, wo solche Erreger kursieren. Gleichzeitig breiten sich die Überträger solch typischer Reisekrankheiten - vor allem Gelsen und Moskitos - durch den Klimawandel aus.
Doch Ärzte in Mitteleuropa denken nicht immer an Tropenkrankheiten, wenn sie einen infizierten Patienten vor sich haben. "Es kommt noch nicht so häufig vor, dass man das in der Praxis sieht", sagt Ulrike Protzer, die das Institut für Virologie der Technischen Universität München (TUM) leitet. So breite sich etwa das insbesondere vor den Olympischen Spielen in Brasilien viel diskutierte Zika-Virus inzwischen langsamer aus, sagt Protzer.
Häufigste Reisekrankheiten
Malaria und Denguefieber hingegen zählen laut Robert Koch-Institut (RKI) zu den häufigsten "reiseassoziierten Krankheiten", mit jeweils rund 1.000 Fällen im vergangenen Jahr in Deutschland. Afrikanische Staaten wie Nigeria und Eritrea gelten als typische Infektionsländer für Malaria. Wobei das RKI betont, dass die hohe Fallzahl zu einem großen Teil durch Flüchtlinge aus Nordafrika bedingt ist. Im asiatischen Raum - etwa beliebten Touristenzielen wie Thailand und Indonesien - infizieren sich dagegen viele Patienten mit Denguefieber.
Beide Krankheiten können tödlich verlaufen. Nach Angaben der Weltgesundheitsorganisation (WHO) starben zum Beispiel 2015 weltweit rund 430.000 Menschen an Malaria. Oliver Hayden vom TUM-Lehrstuhl für Biomedizinische Elektronik hat mit Kollegen bei Siemens einen automatisierten Blutschnelltest entwickelt. Dieser diagnostiziert die Krankheit anhand von 30 Blutwerten mit einer Sicherheit von 97 Prozent. Dafür gab es den Europäischen Erfinderpreis in der Kategorie Industrie.
Um den Bluttest einzusetzen, brauchen Labore nicht einmal neue Geräte: "Die Fülle an Information eines Hämatologie-Automaten wird bisher nur sehr oberflächlich genutzt. Dabei werden 35 Prozent aller klinischen Tests routinemäßig auf hämatologische Parameter geprüft", so Hayden. In der Regel werde eine Blutprobe aber erst dann gründlich untersucht, wenn ein Blutbild außerhalb der Norm liege. Mit einem speziellen Algorithmus für Malaria überprüft Haydens neuer Schnelltest die Blutwerte auf charakteristische Malaria-Muster. Insbesondere die Blutplättchen liefern wichtige Hinweise auf eine solche Infektion.
"Das ist aber kein Test für den Busch", macht Hayden deutlich. Die Geräte seien für Zentrallabore und sogenannte Hochdurchsatz-Analytik mit Tausenden Proben am Tag ausgelegt. Malaria ist nur ein Beispiel, und es sei abzusehen, dass Laborautomaten in Zukunft viel mehr Krankheiten erkennen könnten. Dies unterstütze die Routinediagnostik an den Kliniken.
Virologin Protzer bestätigt, dass inzwischen mehr zu Tropenkrankheiten geforscht und entwickelt wird. So befasse sich das Deutsche Zentrum für Infektionsforschung mit neu auftretenden Krankheiten sowie Impfstoffen und breit einsetzbaren Medikamenten. "Denn bei vielen Viruserkrankungen ist es so, dass man vorbeugen, aber hinterher nicht mehr viel machen kann", sagt sie.
Daher sei eine gute Vorbereitung vor einem Urlaub wichtig. "Ich glaube, dass sich viele nicht wirklich überlegen, was sie sich bei einer Safari einfangen können", sagt Protzer. Das gelte auch für viele Städte in Asien. Zugleich warnt sie vor Panik: "Man muss nicht sofort zum Tropeninstitut gehen." Aber Rückkehrer sollten sich vor dem Besuch beim Hausarzt fragen, ob etwa ein Fieber auch mit der jüngsten Reise zusammenhängen könnte.
Dass solche Überlegungen wichtiger werden, zeigt eine Arbeit der Uni Bayreuth: Am Beispiel des Chikungunya-Virus, das vor allem Asiatische Tigermücken und Gelbfiebermücken übertragen, berechneten Forscher um Carl Beierkuhnlein vom Lehrstuhl für Biogeografie Folgen des Klimawandels. Würde die Erderwärmung ungebremst weitergehen und die globale Mitteltemperatur bis 2100 um etwa 4,8 Grad Celsius im Vergleich zum vorindustriellen Zustand steigen, könnte Chikungunya sich in deutlich mehr Weltregionen ausbreiten. "Das Virus wird dann voraussichtlich bis in die Länder Südeuropas und in die USA vordringen", schreiben die Forscher im Fachblatt "Scientific Reports". "Dieses Szenario ist insofern wahrscheinlicher, als bisher keine globalen Strategien erkennbar sind, die den Klimawandel nachhaltig abschwächen würden", sagt Beierkuhnlein.
"Das ist interessant, weil viele Virusinfektionen und auch Malaria von Mücken übertragen werden", sagt Protzer. Daher sei es wichtig, die Wirkung des Klimawandels auf Reisekrankheiten zu erforschen.
Aber die Bayreuther haben auch Überraschendes herausgefunden: Mit steigenden Temperaturen könnte die Chikungunya-Gefahr in manchen Regionen wie Indien und an den Südrändern der Sahara sinken. Hier könnten die Lebensbedingungen für Stechmücken schlicht zu extrem werden. Ob Touristen aber in solch heiße und trockene Gebiete reisen wollen, ist eine andere Frage.
(Von Marco Krefting/dpa)